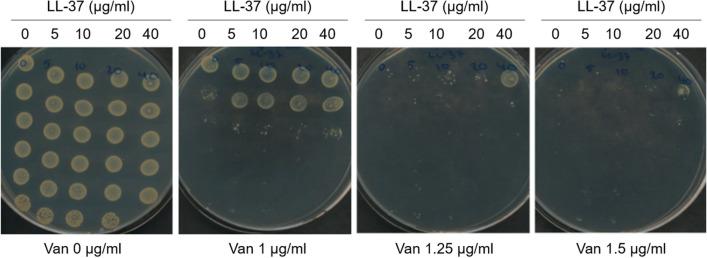
https://cdn.ncbi.nlm.nih.gov/pmc/blobs/e83a/7403302/a2ae66a47569/41598_2020_69962_Fig1_HTML.jpg

人抗菌肽 LL-37 诱导金黄色葡萄球菌对万古霉素的非遗传性易感性降低。
Human antimicrobial peptide, LL-37, induces non-inheritable reduced susceptibility to vancomycin in Staphylococcus aureus.
机构信息
Department of Veterinary and Animal Sciences, University of Copenhagen, Stigbøjlen 4, 1870, Frederiksberg C, Denmark.
Novo Nordisk, Hagedornsvej 1, 2820, Gentofte, Denmark.
出版信息
Sci Rep. 2020 Aug 4;10(1):13121. doi: 10.1038/s41598-020-69962-4.
Antimicrobial peptides (AMPs) are central components of the innate immune system providing protection against pathogens. Yet, serum and tissue concentrations vary between individuals and with disease conditions. We demonstrate that the human AMP LL-37 lowers the susceptibility to vancomycin in the community-associated methicillin-resistant S. aureus (CA-MRSA) strain FPR3757 (USA300). Vancomycin is used to treat serious MRSA infections, but treatment failures occur despite MRSA strains being tested susceptible according to standard susceptibility methods. Exposure to physiologically relevant concentrations of LL-37 increased the minimum inhibitory concentration (MIC) of S. aureus towards vancomycin by 75%, and resulted in shortened lag-phase and increased colony formation at sub-inhibitory concentrations of vancomycin. Computer simulations using a mathematical antibiotic treatment model indicated that a small increase in MIC might decrease the efficacy of vancomycin in clearing a S. aureus infection. This prediction was supported in a Galleria mellonella infection model, where exposure of S. aureus to LL-37 abolished the antimicrobial effect of vancomycin. Thus, physiological relevant concentrations of LL-37 reduce susceptibility to vancomycin, indicating that tissue and host specific variations in LL-37 concentrations may influence vancomycin susceptibility in vivo.
抗菌肽 (AMPs) 是先天免疫系统的核心组成部分,可提供针对病原体的保护。然而,血清和组织中的浓度在个体之间以及疾病状况下存在差异。我们证明人类 AMP LL-37 降低了社区相关耐甲氧西林金黄色葡萄球菌 (CA-MRSA) 菌株 FPR3757(USA300)对万古霉素的敏感性。万古霉素用于治疗严重的 MRSA 感染,但尽管根据标准药敏方法测试 MRSA 菌株敏感,仍会出现治疗失败。暴露于生理相关浓度的 LL-37 将金黄色葡萄球菌对万古霉素的最低抑菌浓度 (MIC) 提高了 75%,并导致在亚抑菌浓度的万古霉素下,迟滞期缩短,菌落形成增加。使用数学抗生素治疗模型的计算机模拟表明,MIC 的微小增加可能会降低万古霉素清除金黄色葡萄球菌感染的疗效。这一预测在大蜡螟感染模型中得到了支持,其中金黄色葡萄球菌暴露于 LL-37 会消除万古霉素的抗菌作用。因此,生理相关浓度的 LL-37 降低了对万古霉素的敏感性,表明组织和宿主特异性的 LL-37 浓度变化可能会影响体内万古霉素的敏感性。